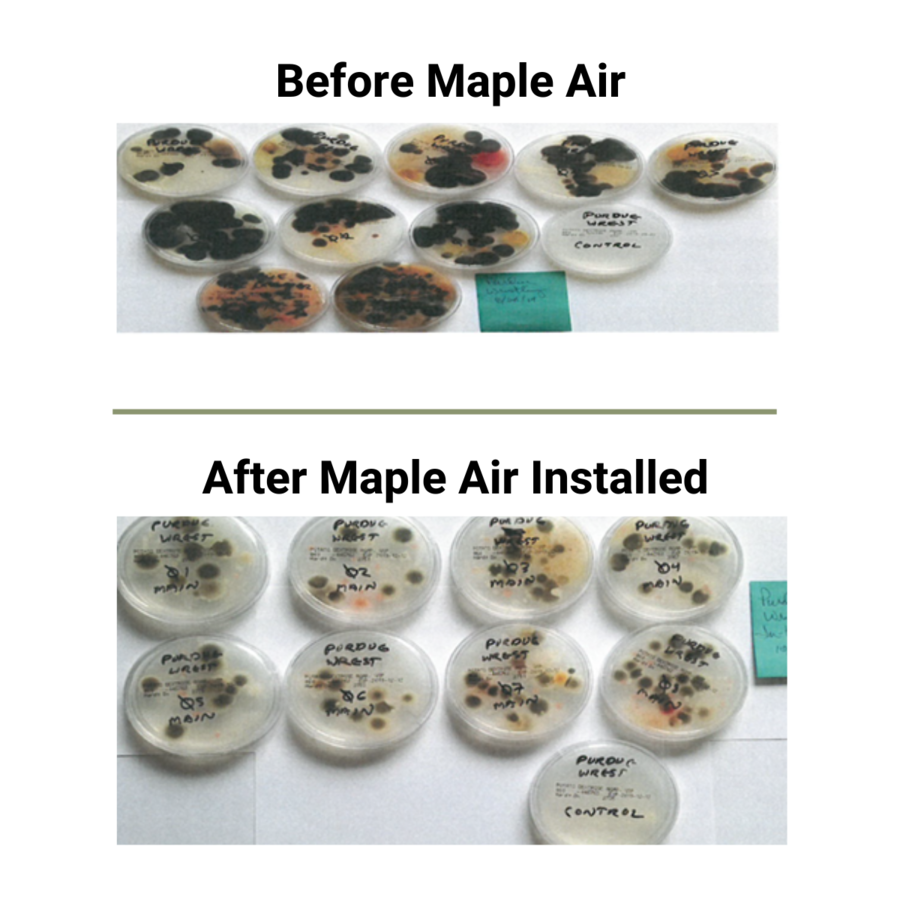

CHARLOTTE, NC, July 17, 2025 /24-7PressRelease/ -- Maple Air is officially launching a rebrand of AIRPHX's proprietary air purification solution, Pür Plasma™, designed for both residential and commercial environments.
Pür Plasma™ has been deployed for almost a decade under the AIRPHX brand as a trusted healthy environment solution in dozens of industries, including schools and universities, gyms, sporting venues, restaurants, hospitality, medical, assisted living, and food processing. Now, a new generation of this technology is available to homeowners and business owners under the Maple Air brand. The system is unmatched in its ability to effectively treat bacteria, viruses, mold, VOCs (like formaldehyde), smoke, odors, and harmful gases such as carbon monoxide, nitrogen oxides, and radon.
Maple Air is available across two product families:
-In-duct units: Installed directly into HVAC ductwork, these systems transform central air systems into powerful purifiers that continuously clean both the air and surrounding surfaces.
-Wall-mounted units: Ideal for commercial facilities, these units deliver the same air and surface purification while allowing business owners to visibly demonstrate their commitment to indoor air quality.
"We believe everyone deserves safe and healthy environments," said Andrew Ip, CEO of Maple Air. "With Maple Air, we've created a solution that is both powerful and practical, using environmentally friendly technology to protect the spaces, people, and patrons that you care about. With deployments throughout the nation, and in several high-stake environments - there is simply no other technology that is as effective in real-world spaces."
Maple Air runs quietly with low energy use, and uses a fully organic, ozone-free, non-degrading and chemical-free process. It is an ideal solution for any occupied space, from a single-family residence to a large format sporting venue, where safe and healthy environments are important.
To learn more about Maple Air, visit: www.getmapleair.com
About Maple Air
Based in McLean, VA and Charlotte, NC, Maple Air offers a proprietary non-thermal, non-equilibrium plasma-based air and surface purification solution that can integrate with an existing HVAC system or be mounted on walls. The company's proprietary Pür Plasma™ technology is highly effective against a wide range of pollutants, including mold, bacteria, viruses, VOCs, other harmful gases, and odors. With a chemical-free, ozone-free, organic approach, Maple Air supports healthier environments in all occupied spaces, including homes, schools, restaurants, healthcare settings, and other commercial spaces. The product is available nationwide at www.getmapleair.com and through a growing list of partners including local Ace Hardware locations, HVAC installers, and other service trades.
# # #
Contact Information
Andrew Ip
Maple Air
Charlotte, NC
United States
Telephone: 833-627-5346
Email: Email Us Here
Website: Visit Our Website
Blog: Visit Our Blog